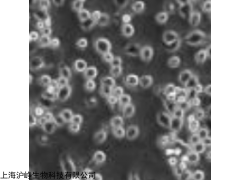
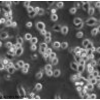

| 提交询价信息 |
| 发布紧急求购 |

价格:电议
所在地:上海
型号:PC-12(高分化)
更新时间:2019-10-10
浏览次数:802
公司地址:上海市,浦东新区,懿行路971弄
![]()
陈经理(女士) 经理(微信与手机号同号)
运输和保存:可选择干冰运输及发送复苏存活细胞方式:(1)干冰运输,收到后立即转入液氮冻存或直接复苏;(2)存活细胞,收到后应继续生长,传代达到细胞生长状态良好时,再进行冻存。具体操作见细胞培养步骤。
细胞用途:仅供科研使用。
方 式: 详询经理

使用权限 A类注意事项:
1. 收到细胞后先观察细胞瓶是否完好,培养液是否有漏液、浑浊等现象,若有上述现象发生请及时和我们。
2. 仔细阅读细胞说明书,了解细胞相关信息,如细胞形态、所用培养基、血清比例、所需细胞因子等。
3. 用75%酒精擦拭细胞瓶表面,显微镜下观察细胞状态。因运输问题贴壁细胞会有少量从瓶壁脱落,将细胞置于培养箱内静置培养过夜,隔天再取出观察。此时多数细胞均会贴壁,若细胞仍不能贴壁请用台盼蓝染色测定细胞活力,如果证实细胞活力正常,请将细胞离心后用新鲜培养基再次贴壁培养;如果染色结果显示细胞无活力,请拍下照片及时和我们,信息确认后我们为您再寄送一次。
4. 请客户用相同条件的培养基用于细胞培养。培养瓶内多余的培养基可收集备用,细胞传代时可以一定比例和客户自备的培养基混合,使细胞逐渐适应培养条件;建议直接购买提供的完全培养基。
5. 建议客户收到细胞后前3天各拍几张细胞照片,记录细胞状态,便于和技术部沟通交流。
培养温馨提示:
1)公司努力实现为科学研究提供实验细胞技术服务。所提供的实验细胞及其子代,不能用于人体实验和临床诊断、治疗。
2)公司细胞资源中心承诺尽努力对实验细胞资源相关信息进行及时更新。但限于我们的技术条件,中心不保证其准确性。
3)从文献等处引用的信息本中心未进行核实,仅供参考。
大鼠肾上腺嗜铬细胞瘤细胞(高分化)科研用
注意事项:
1. 收到细胞后,若发现干冰已挥发干净、冻存管瓶盖脱落、破损及细胞有污染,请立即与我们联系。
2. 所有动物细胞均视为有潜在的生物危害性,必须在二级生物安全台内操作,并请注意防护,所有废液及接触过此细胞的器皿需要灭菌后方能丢弃。
 免责声明:以上所展示的[PC-12(高分化) 大鼠肾上腺嗜铬细胞瘤细胞(高分化)科研用]信息由会员[上海沪峥生物科技有限公司]自行提供,内容的真实性、准确性和合法性由发布会员负责。
免责声明:以上所展示的[PC-12(高分化) 大鼠肾上腺嗜铬细胞瘤细胞(高分化)科研用]信息由会员[上海沪峥生物科技有限公司]自行提供,内容的真实性、准确性和合法性由发布会员负责。